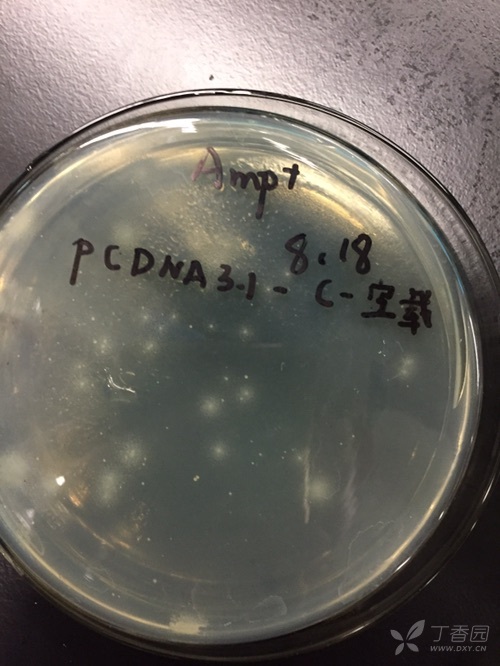
蓝白斑筛选出现片状白斑

蓝白斑筛选图

蓝白斑筛选一种很炫的东西
图片尺寸560x560
图二 蓝白斑筛选中不同片段大小的整合
图片尺寸1076x423
【求助】载体构建 及蓝白斑筛选实验 急需帮助!
图片尺寸1545x1523
蓝白斑筛选法
图片尺寸507x341
记一次失败的蓝白斑筛选
图片尺寸480x640
蓝白筛选的介绍
图片尺寸243x264
基因工程-重组体克隆的筛选和鉴定ppt
图片尺寸1080x810
基因工程重组子筛选-蓝白斑计数
图片尺寸400x232
默克sigma实验分享|蓝白斑筛选和菌落筛选实验方案
图片尺寸810x389
蓝白斑筛选的蓝白斑筛选原理
图片尺寸500x301
哈哈第一次做蓝白斑
图片尺寸1080x810
设计适用于蓝白斑筛选的基因工程菌为β-半乳糖苷酶缺陷型
图片尺寸536x472
蓝白斑筛选的原理是什么?
图片尺寸720x1029
北京华越洋生物
图片尺寸980x880
blue-gal与iptg联合用于蓝/白斑筛选技术原理和应用(提供g级blue-gal)
图片尺寸757x451
农杆菌感受态制作和转化
图片尺寸679x273
【实验】1分钟学会x-gal怎么配,蓝白斑筛选怎么做,iptg怎么配_哔哩
图片尺寸986x616
蓝白斑筛选出现片状白斑
图片尺寸500x666
分子生物学 蓝白斑筛选原理
图片尺寸863x540
蓝白斑筛选的原理
图片尺寸2304x1440